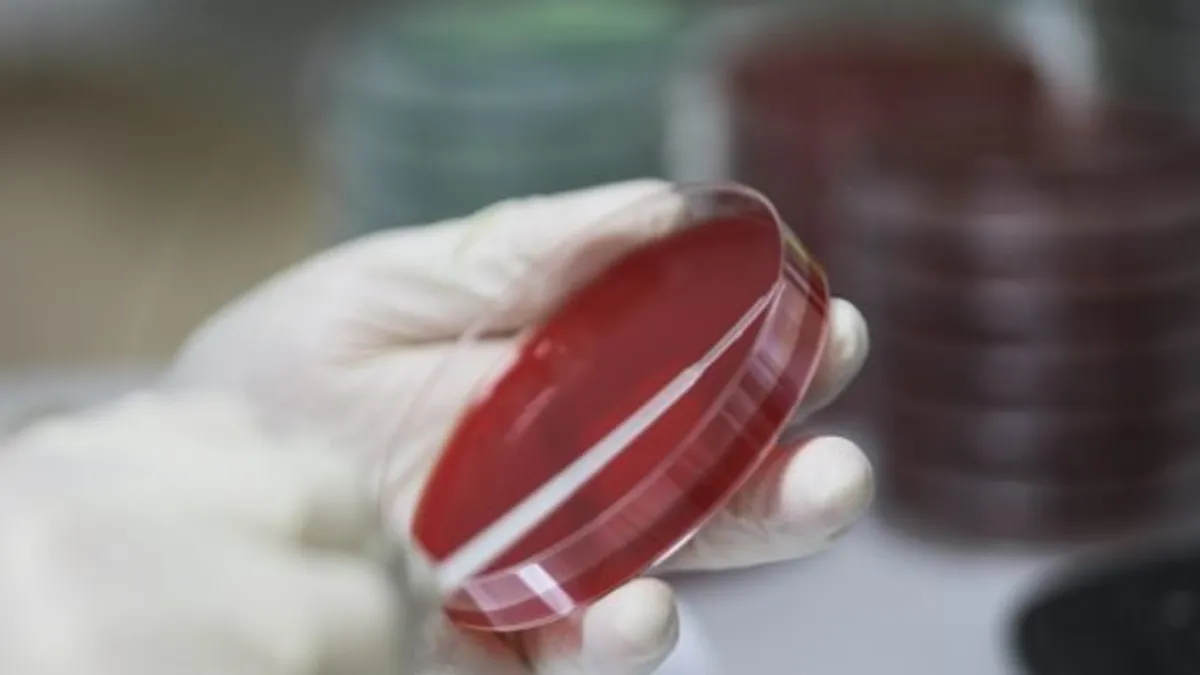
Focar de antrax lângă Iași, pericol (sursa: ziaruldeiasi.ro)

Focar de antrax lângă Iași, măsurile luate pentru a preveni un dezastru nu sunt suficiente, avertizează medici din DSP
Focar de antrax lângă Iași, pericol. Mai multe surse din Direcția de Sănătate Publică Iași au explicat că este posibil să stăm, în momentul de față, pe un focar de antrax și măsurile luate să nu fie suficiente.
Focar de antrax lângă Iași, pericol
Sursele noastre au precizat că este "aproape imposibil" să nu existe o legătură între cele trei suspiciuni de antrax din urmă cu două săptămâni de la Movileni și cazul de la Țigănași, de săptămâna trecută.
Asta, deși probele trimise la București au ieșit negative, în cazul Movileni, atât pentru cei trei pacienți internați la Spitalul de Boli Infecțioase din Iași, cât și pentru carcasele de bovine descoperite îngropate și incinerate în localitate.
Dar proba pentru carcasa de capră din Țigănași a ieșit pozitivă, iar pentru persoana infectată rezultatele sunt încă în lucru.
Continuarea, în Ziarul de Iași.

























